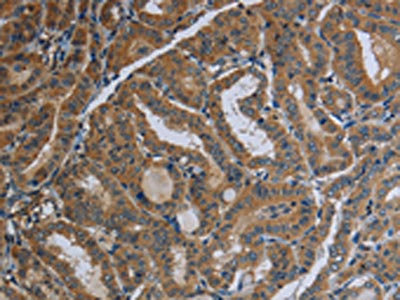

FAAH Antibody
-
中文名稱:FAAH兔多克隆抗體
-
貨號:CSB-PA589232
-
規格:¥1100
-
圖片:
-
The image on the left is immunohistochemistry of paraffin-embedded Human thyroid cancer tissue using CSB-PA589232(FAAH Antibody) at dilution 1/40, on the right is treated with fusion protein. (Original magnification: ×200)
-
The image on the left is immunohistochemistry of paraffin-embedded Human brain tissue using CSB-PA589232(FAAH Antibody) at dilution 1/40, on the right is treated with fusion protein. (Original magnification: ×200)
-
-
其他:
產品詳情
-
Uniprot No.:
-
基因名:FAAH
-
別名:FAAH; FAAH1; Fatty-acid amide hydrolase 1; Anandamide amidohydrolase 1; Fatty acid ester hydrolase; Oleamide hydrolase 1
-
宿主:Rabbit
-
反應種屬:Human,Mouse,Rat
-
免疫原:Fusion protein of Human FAAH
-
免疫原種屬:Homo sapiens (Human)
-
標記方式:Non-conjugated
-
抗體亞型:IgG
-
純化方式:Antigen affinity purification
-
濃度:It differs from different batches. Please contact us to confirm it.
-
保存緩沖液:-20°C, pH7.4 PBS, 0.05% NaN3, 40% Glycerol
-
產品提供形式:Liquid
-
應用范圍:ELISA,IHC
-
推薦稀釋比:
Application Recommended Dilution ELISA 1:2000-1:5000 IHC 1:50-1:200 -
Protocols:
-
儲存條件:Upon receipt, store at -20°C or -80°C. Avoid repeated freeze.
-
貨期:Basically, we can dispatch the products out in 1-3 working days after receiving your orders. Delivery time maybe differs from different purchasing way or location, please kindly consult your local distributors for specific delivery time.
-
用途:For Research Use Only. Not for use in diagnostic or therapeutic procedures.
相關產品
靶點詳情
-
功能:Catalyzes the hydrolysis of endogenous amidated lipids like the sleep-inducing lipid oleamide ((9Z)-octadecenamide), the endocannabinoid anandamide (N-(5Z,8Z,11Z,14Z-eicosatetraenoyl)-ethanolamine), as well as other fatty amides, to their corresponding fatty acids, thereby regulating the signaling functions of these molecules. Hydrolyzes polyunsaturated substrate anandamide preferentially as compared to monounsaturated substrates. It can also catalyze the hydrolysis of the endocannabinoid 2-arachidonoylglycerol (2-(5Z,8Z,11Z,14Z-eicosatetraenoyl)-glycerol). FAAH cooperates with PM20D1 in the hydrolysis of amino acid-conjugated fatty acids such as N-fatty acyl glycine and N-fatty acyl-L-serine, thereby acting as a physiological regulator of specific subsets of intracellular, but not of extracellular, N-fatty acyl amino acids.
-
基因功能參考文獻:
- the interaction between NAPE-PLD rs12540583 and FAAH rs324420, rs2295633 and rs6429600 is associated with schizophrenia. PMID: 29652995
- This study demonstrated that a significant association was observed between FAAH SNP genotype and self-report pain measures, mechanical and cold pain sensitivity among LBP participants. PMID: 28481838
- The FAAH levels were lower in the polycystic ovary syndrome(PCOS) group than the non-PCOS group. FAAH levels in secretory phases were significantly elevated compared to menstrual and proliferative phase. Dysregulation of the endocannabinoid system may result in PCOS. PMID: 28132572
- FAAH variants have shown a robust gene-environment interaction, namely, significantly higher anxiety and depression scores were exhibited by individuals carrying the A allele PMID: 27005594
- High FAAH expression is associated with lung neoplasms. PMID: 26930716
- study demonstrates a dose-dependent relationship between chronic cannabis use and reported sleep quality, independent of abstinence length. Furthermore, it provides novel evidence that depressive symptoms mediate the relationship between FAAH genotype and sleep quality in humans. PMID: 27074158
- FAAH was significantly associated with DSM-5 cannabis use disorder group count (DSM-5 CUD) using a gene-based test (p = 0.0035). This association survived Bonferroni correction for multiple testing at p < 0.004. Post hoc analyses suggested this association was driven by two common (minor allele frequency >5%) SNPs in moderate linkage disequilibrium, rs324420 and rs4141964, at p = 0.0014 and p = 0.0023, respectively. PMID: 27394933
- We first report loss-of-function mutations in DGAT2 and FAAH in one obese subject, which may interact with each other to affect the adiposity penetrance, providing a model of genetic interaction associated with human obesity. PMID: 28243972
- This study suggests that interactions between anandamide and CRF1 represent a fundamental molecular mechanism regulating amygdala function and anxiety. PMID: 26923505
- In cannabis users, fatty acid amide hydrolase binding was significantly lower across the brain regions examined than in matched control subjects. Lower binding was negatively correlated with cannabinoid concentrations in blood and urine and was associated with higher trait impulsiveness. PMID: 27345297
- We investigated the relationship between variation in the CNR1, CNR2, and FAAH genes and change in primary anxiety disorder severity. Five SNPs were nominally associated with a poorer treatment response (rs806365 [CNR1]; rs2501431 [CNR2]; rs2070956 [CNR2]; rs7769940 [CNR1]; rs2209172 [FAAH]) and one with a more favorable response (rs6928813 [CNR1]). PMID: 27346075
- C385A variation modulates stress responses in subjects with posttraumatic stress disorder and alcohol dependence PMID: 27716956
- REVIEW: role in pain and pain treatment PMID: 27240888
- the presence and differential distribution of fatty acid amide hydrolase (FAAH) and monoglyceride lipase (MGLL) in relation to CB1 during the maturation of human oocytes, was investigated. PMID: 26948343
- fatty acid amide hydrolase inhibition exerts cutaneous anti-inflammatory effects PMID: 26738935
- In transgenic mice, a direct involvement of the human FAAH C385A SNP was associated with alcohol "binge" drinking. PMID: 26857901
- Results suggest that carriers of FAAH A allele are at increased risk of Myocardial Infarction. PMID: 25270105
- FAAH gene variation was shown to associate with cold pain sensitivity with P129T/rs324420 being the most likely causal variant as it is known to reduce the FAAH enzyme activity. PMID: 26808012
- Data suggest that subjects who are carriers of minor allele (A) at missense mutation rs324420 in FAAH benefit from increased consumption of oleic and docosahexaenoic acids in dietary treatment of abdominal obesity. PMID: 26806592
- Specific FAAH polymorphisms are associated with refractory postoperative nausea and vomiting , opioid-related respiratory depression, and prolonged PACU stay due to opioid adverse effects in white children undergoing tonsillectomy. PMID: 25558980
- the FAAH 385C>A polymorphism may have a role in the endocannabinoid-related obesity phenotype PMID: 26561012
- Cannabis-using FAAH C/C carriers and A carrying controls have reduced white matter integrity compared to control C/C carriers. PMID: 26106535
- Studied the mechanism of FAAH for lipid selection to specifically hydrolyze anandamide, examining the role of the dynamic paddle formed at the boundaries of the FAAH catalytic site. PMID: 26111155
- FAAH genetic variation enhances fronto-amygdala function regarding fear regulation in mouse and human. PMID: 25731744
- no significant differences between preeclamptic and normal placenta in terms of CB2 and FAAH expressions and immunoreactivity PMID: 25444073
- evidence that the genetic variant rs324420 in FAAH is associated with measurable differences in brain FAAH binding as per PET [(11)C]CURB measurement. PMID: 26036940
- fatty acid amide hydrolase activity decreases in the frontal cortex from patients with Alzheimer's disease PMID: 25456842
- High FAAH expression is associated with drug resistance in non-small cell lung cancer. PMID: 24811863
- In subcutaneous adipose tissue, DAGL-a mRNA was upregulated and fatty acid amide hydrolase (FAAH) and monoacylglycerol lipase (MAGL) mRNAs were down-regulated in obese subjects, but the diets had no influence. PMID: 24616451
- Single nucleotide polymorphism in the FAAH gene was not associated with IBS pathogenesis. PMID: 24444427
- FAAH Pro129/Pro129 homozygotes, reported higher placebo analgesia and more positive affective states immediately and 24 h after placebo administration; no effects on pain report in the absence of placebo were observed. PMID: 24042479
- It controls intestinal motility through its putative receptors or non-receptor-mediated pathways. Thus, Decreased enteric fatty acid amide hydrolase activity is associated with colonic inertia in slow transit constipation. PMID: 23926887
- Subjects with C385C genotype of the FAAH showed an improvement on insulin and HOMA-R levels with a high polyunsaturated fat hypocaloric diet after weight loss during 3 months PMID: 24445122
- In obese humans, FAAH or MGL activity in adipocytes is not affected by diabetes, dyslipidaemia or other markers of metabolic dysfunction. PMID: 24593280
- FLAT does not serve as a global intracellular AEA carrier PMID: 24223930
- Suggest anandamide and FAAH as direct modifiers in signalling mediated activation of Nrf2-HO-1 pathway. PMID: 23347118
- our results indicate that the FAAH C385A SNP is one of the most promising candidates for individuals who are at higher risk for alcohol problems. PMID: 24407958
- The findings support an association with CNR1 and FAAH genes and marijuana-related problems among regular marijuana users PMID: 24172113
- the C385A polymorphism of the fatty acid amide hydrolase gene is not a genetic susceptibility factor for the development of polycystic ovary syndrome. PMID: 23616186
- genetic association study in population in Spain: Data suggest SNP in FAAH (C385A, rs324420) is associated with response of obese subjects to reducing diet which is high in monounsaturated fats; weight loss is higher in subjects with C385C genotype. PMID: 23333123
- Our findings suggest that the FAAH Pro129Thr polymorphism may contribute to methamphetamine dependence in the Malay and Chinese ethnic groups PMID: 23556448
- The differential expression of NAPE-PLD and FAAH suggests that Anandamide could play an important role in the pathophysiology of preeclampsia. PMID: 23122699
- FAAH A carriers, compared to C/C carriers, exhibited increased startle potentiation and emotional responsiveness towards unpleasant picture stimuli, and reduced startle inhibition indicating reduced emotional reactivity in response to pleasant pictures PMID: 22776995
- Elevated endocannabinoid levels and reduced FAAH activity are associated with ectopic pregnancy and may modulate tubal function, suggesting dysfunctional endocannabinoid action in ectopic implantation. PMID: 23372171
- Mapping human brain fatty acid amide hydrolase activity with PET. PMID: 23211960
- FAAH expression increase steadily after infancy, peaking in adulthood. PMID: 22827915
- our data suggest that FAAH has an important role in PTSD through modulation of aversive memories and point to both a novel therapeutic target and a possible risk marker. PMID: 22832737
- genetic association studies in a population in Spain: Data suggest that an SNP in FAAH (rs324420) is not associated with response/resistance or remission/no remission with citalopram treatment in patients with major depressive disorder. PMID: 22826533
- There is a lack of association of the FAAH genotypes with metabolic syndrome prevalence. PMID: 22609216
- Cannabinoid receptors and endocannabinoid modulating enzymes were localized in fallopian tube epithelium by immunohistochemistry and showed reduced CB1 and FAAH expression in ectopic pregnancy PMID: 22701012
顯示更多
收起更多
-
亞細胞定位:Endomembrane system; Single-pass membrane protein. Cytoplasm, cytoskeleton. Note=Seems to be attached to intracellular membranes and a portion of the cytoskeletal network.
-
蛋白家族:Amidase family
-
組織特異性:Highly expressed in the brain, small intestine, pancreas, skeletal muscle and testis. Also expressed in the kidney, liver, lung, placenta and prostate.
-
數據庫鏈接:
Most popular with customers
-
-
YWHAB Recombinant Monoclonal Antibody
Applications: ELISA, WB, IHC, IF, FC
Species Reactivity: Human, Mouse, Rat
-
-
-
-
-
-